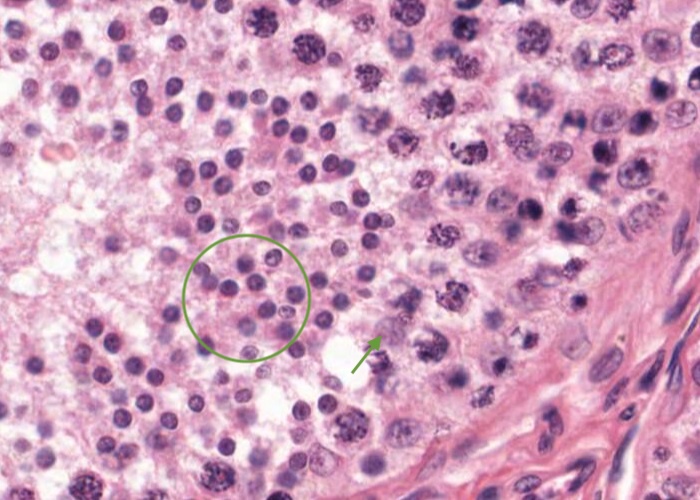
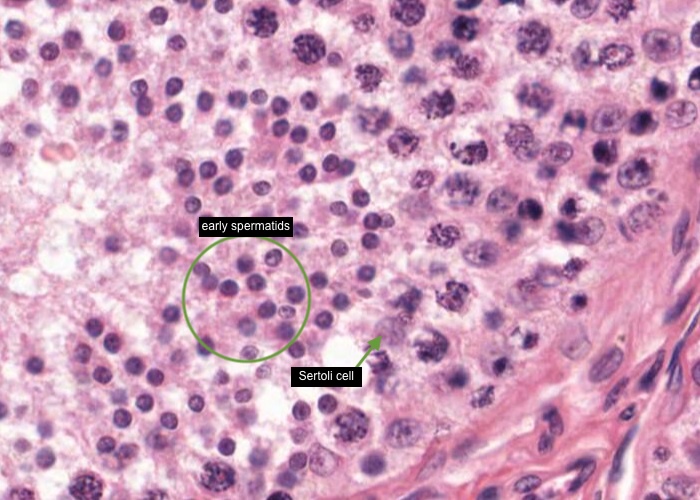

ANHB2214 Male Reproductive System
1/38
There's no tags or description
Looks like no tags are added yet.
Name | Mastery | Learn | Test | Matching | Spaced | Call with Kai |
|---|
No analytics yet
Send a link to your students to track their progress
39 Terms


Note the eosinophilic, thick, outer capsule, the tunica albuginea. To one side you can see the cross-section of the ductus epididymis outside the tunica albuginea. Be sure to locate these structures under low magnification when you examine the histological section. Note especially, within the testis, the many sections through seminiferous tubules and be sure you examine their complex stratified epithelium which is described in an item "Seminiferous tubule" that follows.
The tunica albuginea is thickened posteriorly to form the mediastinum testis (which has not been sectioned here). From the mediastinum connective tissue septa radiate from this capsule to subdivide the testis into approximately 250 compartments – the lobuli testis. Within the lobuli testis sectioned profiles of the seminiferous tubules will be examined in the items to follow as well as the tubuli recti, rete testis and ductus epididymis adjacent to the mediastinum.


Observe the thick, fibrous, connective tissue surrounding the testis – the tunica albuginea. The inner component of this capsule is a vascular network called the tunica vasculosa from which blood vessels penetrate into the testis. The tunica albuginea is thickened posteriorly to form the mediastinum testis where blood and lymphatic vessels and excurrent ducts enter or exit the testis.


The coiled seminiferous tubules (which may be cut many times in transverse, oblique, or longitudinal section) consist of a sheath of fibrous connective tissue, a basal lamina and a complex stratified seminiferous epithelium.
Tubules are separated by loose connective tissue rich in blood vessels, lymphatics and nerves. This interstitial connective also contains interstitial cells of the testis (Leydig cells), and often shrinks during the preparation of histological slides and clear spaces (artefact) result in the section.


A type A dark (Ad) spermatogonium has an ovoid nucleus with granular chromatin. They are probably the stem cells of the seminiferous epithelium and located adjacent to the basement membrane of the tubule.


A type A pale (Ap) spermatogonium is also located adjacent to the tubule basement membrane and also has an ovoid nucleus but with light staining, granular chromatin. These Ap cells are destined to differentiate into spermatozoa.

A

ype B spermatogonium has a spherical nucleus with clumped chromatin. These spermatogonia have arisen from subsequent divisions of the Ap cells.


Your aim here is to examine the seminiferous epithelium and identify the spermatogenic cells in the histological section of the testis. You have already looked for spermatogonia and know they occupy the basal compartment.
These spermatogonia give rise to the primary spermatocyte generation of spermatogenic cells. These cells will then move away from the basement membrane of the seminiferous epithelium and occupy the adluminal compartment. They form occluding junctions with the supporting Sertoli cell that are also present in the epithelium - you will learn about them in another item in this module.
A primary spermatocyte is easy to recognize because of its large size (or more accurately the large size of its nucleus). It is often difficult to discern their cytoplasm which blends in with that of any nearby Sertoli cell. You can actually see individual chromosomes as they condense in their nuclei (a geneticist's dream). On the basis of their degree of condensation, it will be possible for you to find some regions which have both an early and late primary spermatocyte layered on each other but do not overly concern yourself with this detail.


As you have just realised, primary spermatocytes are the largest cells in the seminiferous tubule. They differentiate from mitotic division of diploid spermatogonia then enter the first meiotic division to form secondary spermatocytes which quickly enter a second meiotic division to form a spermatid which will be supported by Sertoli cells and eventually cluster near the tubule lumen as immature spermatozoa. Thus, the primary spermatocytes have reduced their chromosome complement to form the haploid spermatid.
Secondary spermatocytes have half the volume of primary spermatocytes. They divide soon after being formed. Therefore, you probably will not see this stage. The best place to look, of course, would be in a region that contains primary spermatocytes in division. These you can see. Cells in meiotic division have very eosinophilic cytoplasm, and their chromosomes cluster into a dense irregular clump. When you view the histological section, maximize the magnification and examine the dividing cells. They may be in either the first or second division of meiosis and you may see some secondary spermatocytes nearby. The metaphase plate looks like a black irregular blob within the cell.

Spermatids show an amazing range of appearances as they differentiate, going from what look like normal (albeit small) cells (early spermatids) to structures that look like mature sperm (late spermatids). All of this occurs without further cell division. They do not become spermatozoa (sperm) until they are released from the epithelium. Until then, spermatids have an intimate relationship with the Sertoli cell, anatomically and physiologically. As expected spermatids populate the uppermost layers of seminiferous epithelium. The maturing spermatids appear to be embedded within the apical end of the Sertoli cell but it is impossible to see that detail in this image because of the limit of resolution of a light microscope.


During spermiogenesis, spermatids form a flagellum and shed a lot of cytoplasm (which is phagocytosed by Sertoli cells). Late spermatids are still associated with Sertoli cells but eventually will be released into the lumen of the seminiferous tubule.
The Sertoli cell is easy to find once you know what to look for and although it is described in the next item there is a typical one in this image. Find a cell nucleus that is pyramidal in shape and also contains a prominent nucleolus - that is the nucleus of a Sertoli cell! Of course sometime you will see their nuclei appearing as a more rounded shape depending on the plane of section but usually you will see the nucleolus.


Examine the cells of the seminiferous tubule to identify the Sertoli cell. The nucleus is aligned vertically in the seminiferous epithelium. You can recognize them by their pale-staining (euchromatic - so very active), large, irregular-shaped nuclei and a prominent (bright pink/crimson) nucleolus. However, their lateral boundaries will be difficult to trace. The apical region of the cell consists of fine cytoplasmic processes which support the cells of the spermatogenic lineage. Look at enough examples to be able to identify the Sertoli cell with ease.


The tunic of the tubules, really a tunica (lamina) propria, is composed of thin fibrous connective tissue. An elongated nucleus of a myoid cell can be seen regularly within this tunic and these cells are referred to as peritubular contractile cells. Beyond the tunica propria extensive blood vessels and lymphatic vessels are present – and interstitial cells of the testis (Leydig cells).


Within spaces between seminiferous tubules are normal connective tissue elements and a rich vascular network, which is a continuation of the tunica vasculosa – the vascular capsule around the testis (an inner layer of the tunica albuginea).
Located within the connective tissue elements between the seminferous tubules are interstitial cells of the testis (Leydig cells). These are large, steroid-secreting cells and so they have extensive agranular (smooth) endoplasmic reticulum which accounts for their eosinophilic cytoplasm containing droplets of lipid (that are removed by the processing methodology for this H&E section).


The section stained with iron haematoxylin is also excellent for observing the interstitial cells of the testis (Leydig cell). These cells cluster in the connective tissue between the seminiferous tubules. They are the source of testosterone. The cells are plump, with round open nuclei and cytoplasm that looks foamy due to numerous droplets of lipid.


Seminiferous tubules form a loop within each lobule. The ends of the loop in the mediastinum are short and are called the tubuli recti. This short, straight, terminal end of the seminiferous tubule is lined only by Sertoli cells then abruptly changes to simple cuboidal epithelium. These tubules empty into the rete testis.
In the mediastinum of the testis, you can locate areas of the tubuli recti and the rete testis characterized by basophilic, low columnar to cuboidal epithelium - see details in the next two items.


Seminiferous tubules form a loop within each lobule. The ends of the loop in the mediastinum are short and are called the tubuli recti. This short straight terminal end of the seminiferous tubule is lined only by the Sertoli cell then abruptly changes to simple cuboidal epithelium. These tubules empty into the rete testis.


In the mediastinum of the testis you can locate areas of the tubuli recti and the rete testis characterized by basophilic, low columnar epithelium to cuboidal epithelium. An interesting feature of this epithelium is that it does not rest on a lamina propria. The connective tissue below it is just the unspecialized dense irregular connective tissue of the tunica albuginea. A lamina propria is not just any old connective tissue lying below an epithelium; it has to be a layer of underlying connective tissue that is specialized to support the epithelium above it.


From the mediastinum testis, connective tissue septa radiate from this capsule to subdivide the testis into approximately 250 compartments – the lobuli testis. A lobule is seen in this image with about 20 profiles (don't count them!) of seminiferous tubule/s bound by a connective tissue septum in the upper region of the image and another in the lower, left corner region of the image. Two large blood vessels are housed within the septum and will branch further and supply the seminiferous tubules.


The epididymis is made up of two sets of ducts encased in a connective tissue capsule. A dozen or so efferent ducts drain the rete testis and coalesce into a single larger duct of the epididymis. Both types of ducts are highly convoluted. You can distinguish the two unmagnified by noting the size of the tubules at the two ends of the epididymis. Both types of tubules are lined by pseudostratified epithelium, but of distinctive appearances.
In this image, there are numerous profiles of the sectioned, highly coiled, head region of the ductus epididymis. These profiles appear as many shapes depending on how the coiled duct is sectioned.
Maturing spermatozoa are visible (as dark profiles) in the lumens of these profiles.
The next image provides you with details of the histological stucture of the wall, and epithelium lining the lumen, of the ductus epididymis.


Between 10-20 short tubules (ductuli efferentes) carry spermatozoa from the rete testis to the ductus epididymis (so they pierce the tunica albuginea). Both ducts are highly convoluted.
The efferent ducts are distinguishable by the irregular contour of their lumina created because of alternate clustering of non-ciliated, cuboidal cells and taller (columnar), or pseudostratified columnar, ciliated cells.
The epithelial surface of each ductule is supported by a thin basement membrane and the wall of each ductule is composed of thin layers of loose connective tissue and circularly arranged smooth muscle cells. Efferent ducts continue as the ductus epididymis.


The epithelium of the duct of the epididymis is tall with a uniform thickness. It has two cell types, principal cells (tall columnar cells) each with an elongated nucleus and basal cells (each with a rounded nucleus). You may also see a migrating lymphocyte (halo cell). The principal cells have very long, non-motile, branching cell processes, inappropriately called stereocilia, since they are actually long, modified microvilli. These increase the apical surface area of the cell tremendously for resorption of testicular fluid. Non-motile sperm are stored in this duct and in its extension called the vas deferens. When you examine the histological section you will see dense aggregations of these immature sperm in some cuts through the duct of the epididymis.
The lamina propria around the duct of the epididymis has a small amount of smooth muscle, fibroblasts and capillaries. The circular arrangement of these cells is evident.


As the duct proceeds down towards the tail of the epididymis, the amount of smooth muscle in its wall increases. The circular layer remains but added are an inner layer and outer longitudinal layer, to finally develop a huge, well-organized muscularis layer where it becomes the ductus (vas) deferens.
Notice where the wall of the ductus epididymis has been cut more obliquely, the epithelium and muscularis appear thicker than they appear when cut more transversely.
During ejaculation the muscle layer contracts in peristaltic waves. Sperm stored in the part of the epididymis or vas deferens with enough smooth muscle for effective peristalsis will be swept along to become part of the ejaculate. Those sperm in the part of the duct of the epididymis with a smooth muscle layer too poorly developed to be effective will have to wait for another time.
The spermatic cord connects the testis with the rest of the body.
In addition to the ductus (vas) deferens, the spermatic cord carries the vascular and neural supply to and from the testis as well as some longitudinally disposed striated muscle fibres of the cremaster muscle. The plexus of pampiniform veins are particularly prominent and arranged to form a countercurrent heat exchange with the arteries to cool the blood before it reaches the testis. The veins are muscular and not that easy to distinguish from the arteries (so I have guessed here!).
All of these structures are wrapped up in a dense connective tissue sheath, only partly preserved here. The sheath has been cut to allow the fixative to penetrate the tissue but it also has allowed the contents inside to spill out.
The ductus (vas) deferens is recognizable by the extraordinary amount of smooth muscle below the mucosa. I guess you were expecting this as more layers of smooth muscle are added to the ductus epididymis as it proceeds from "head to tail".
The mucosa of this duct is thrown into several longitudinal folds, to allow the lumen to expand during ejaculation.
The epithelium is similar to that lining the ductus epididymis, i.e. tall pseudostratified columnar with stereocilia (modified microvilli) and basal cells (each with a rounded nucleus) sitting on the basement membrane.
The muscularis is organized into three easily distinguished layers; inner and outer longitudinal layer, and middle circular layer - which is continued from way back in the efferent ducts.
The prostate gland is actually a large collection of tubuloalveolar glands of various sizes arranged in three concentric layers. The layers are not clearly defined in this image but are inner mucosal, intermediate submucosal and a peripheral layer. Their secretory epithelium lines both the secretory alveoli and the ducts. The ducts have the larger cross section because it is here that the secretion is stored. The prostatic urethra has a distinctive crescent cross section because a ridge of tissue, the verumontanum, protrudes into the posterior side.
The ducts of the inner mucosal glands empty into the urethra at the cusp of the crescent. If you look in this region, you can see sections through some of them.
You should note when you view this section, the great amount of smooth muscle in the connective tissue between the glands, a characteristic feature of this organ. It can squeeze the whole gland rapidly during ejaculation.
The glandular part of the prostate may look somewhat similar to the seminal vesicle. However, the two differ fundamentally in morphology. The seminal vesicle is a hollow tube with elaborately fluted mucosal projections. The prostate gland has compound alveolar glands embedded in a dense muscular connective tissue.
As a final detail more of interest than of functional significance, you can see a small lumen in the middle of the verumontanum. This is called the utriculus and it is the male homologue of the uterus of the female!
The prostatic urethra is lined with transitional epithelium (urothelium). Ducts from the ejaculatory ducts and small prostatic ducts join this epithelium. Note red blood cells (erythrocytes) in capillaries in the lamina propria.
The epithelium of the glands is useless for distinguishing the prostate. It is generally simple columnar but also is pseudostratified columnar in young males but regresses to simple cuboidal in the elderly. I'll let you be the judge when you examine the histological section.
Another characteristic feature of the prostate gland is the presence of insoluble prostatic concretions (corpus amylacea). These grow by accretion of layer upon layer of precipitated material. When sectioned the concretions often show rings like the growth rings of a tree. Concretions increase in number and size with age but are considered to be a "normal" feature of the prostate gland, since they cause no medical problems. They can be useful for confirming that a section is of prostate tissue but as you will see when you examine this particular section, they can be scarce.
The seminal vesicle contributes an important component of semen. It is a simple tubular gland about ten centimetres long coiled up in a corkscrew fashion. In this image it is sectioned several times. Notice the large lumen. Secretion is stored as it accumulates between ejaculations.
The elaborate mucosa is a dazzling and beautiful set of folds. Try to imagine what they are like in three dimensions. These convolutions greatly increase the area of the secretory epithelium.
The epithelial cells (pseudostratified columnar/cuboidal) are secretory. The activity of the gland and the appearance of the epithelium are controlled by the level of circulating testosterone and thus vary with the age of the individual.
Observe a very well developed muscularis layer in which you might distinguish an inner circular and outer longitudinal smooth muscle layer. Beyond the muscularis is a fibrous coat.
A penis consists of three cylindrical masses of erectile tissue. Two dorsal masses of tissue, the corpora cavernosa, lie side by side and contain large irregularly shaped vascular spaces. A single corpus spongiosum runs ventrally and contains the urethra. The corpus spongiosum will expand distally to form the glans penis. A dense fibrous coat, the tunica albuginea, surrounds each corpus.
The erectile tissue itself comprises a network of large, thin-walled veins (cavernous sinuses) separated by septae of connective tissue. These sinuses receive arterial blood directly. The smooth muscle in the tunica media of these arteries relaxes upon parasympathetic stimulation, allowing blood to rapidly fill the venous sinuses. Later, this blood drains into veins which traverse the tunica albuginea. The draining veins pass through the tunica albuginea at an angle so that as blood distends the cylinders of erectile tissue it pinches off its venous exit, helping to maintain erection. In your mind compare this to the hypothetical situation if veins drained radially through the capsule.
You can easily see the nuclei of the endothelium lining the cavernous spaces and the bands of smooth muscle in the partitions between them.
One important feature of the corpus spongiosum is that it never becomes as firmly erect as the two corpora cavernosa. It becomes engorged with blood but not rigid. This is essential, otherwise it would occlude the urethra just at the wrong time. You should recall that an unyielding connective tissue capsule is necessary for erection. You will be able to see in your section that the tunica albuginea of the corpus spongiosum is thinner than that of the other two corpora. This is one reason why it is incapable of complete erection. Another structural difference that you will be able to see is that the cavernous sinuses are much smaller in the corpus spongiosum.
The tunica albuginea is a dense fibroelastic capsule.
The penile urethra has a flattened, star-shaped lumen surrounded by pseudostratified columnar epithelium except at its most distal end where it becomes continuous with the stratified squamous epithelium of the penile skin. It collapses when not in use by forming a series of longitudinal folds. Note the infiltration of lymphocytes into the lamina propria here and there. This also is an excellent place to examine plasma cells.
The duct of each bulbourethral gland and urethral gland (mucus secreting glands of Littre) open into the penile urethra.